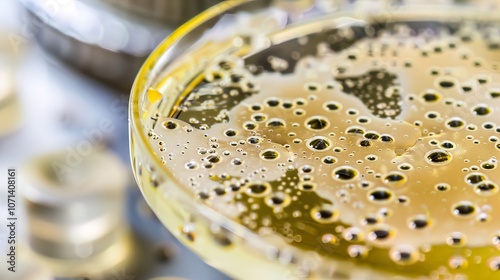

Download sample
File Details
Published: 2024-11-09 06:54:53.768753 Category: Science Type: Illustration Model release: NoShare
Close-up of microscope slide revealing intricate fungal spores, essential for research on fungal diseases and microbiology studies.
Contributor: Steve
ID : 1071408161
